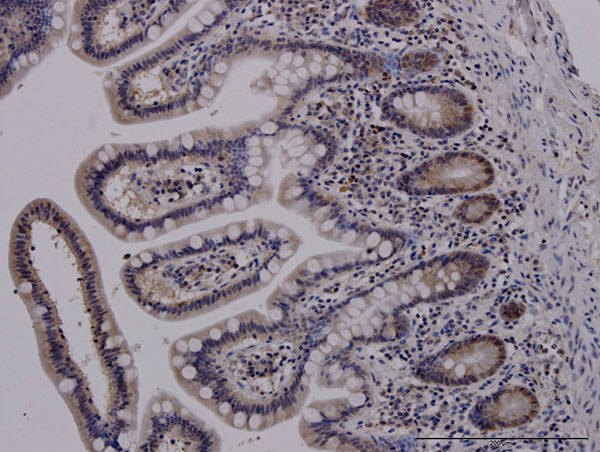
ADAM17 Antibody in Immunohistochemistry (Paraffin) (IHC (P))

Search
Abnova
ADAM17 Monoclonal Antibody (1F6)
{{$productOrderCtrl.translations['antibody.pdp.commerceCard.promotion.promotions']}}
{{$productOrderCtrl.translations['antibody.pdp.commerceCard.promotion.viewpromo']}}
{{$productOrderCtrl.translations['antibody.pdp.commerceCard.promotion.promocode']}}: {{promo.promoCode}} {{promo.promoTitle}} {{promo.promoDescription}}. {{$productOrderCtrl.translations['antibody.pdp.commerceCard.promotion.learnmore']}}
产品信息
H00006868-M01J
宿主/亚型
分类
类型
克隆号
抗原
偶联物
形式
浓度
规格
保存条件
运输条件
产品详细信息
Sequence of this protein is as follows: RADPDPMKNT CKLLVVADHR FYRYMGRGEE STTTNYLIEL IDRVDDIYRN TSWDNAGFKG YGIQIEQIRI LKSPQEVKPG EKHYNMAKSY PNEEKDAWDV
Cell culture grade monoclonal antibodies are obtained by purifying "hybridoma culture medium" which completely eliminates any contamination of mice. They have high affinity, high purity, and no contamination.
靶标信息
ADAM17 (disintegrin and metalloproteinase domain-containing protein 17) cleaves the membrane bound precusor of TNF-alpha to its mature soluble form. ADAM 17 is responsbile for the proteolytical release of soluble JAM3 from endothelial cells surface and the proteolytic release of several other cell-surface proteins, including p75 TNF-receptor, interleukin receptor type II, p55 TNF-receptor, transforming growth factor-alpha, L-selectin, growth hormone receptor, MUC1, and the amyloid precursor protein. It acts as an activator of the Notch pathway by mediating cleavage of Notch and generating the membrane-associated intermediate fragment called Notch extracellular truncation (NEXT). Mutations in the gene can result in inflammatory skin and bowel disease, neonatal 1.
仅用于科研。不用于诊断过程。未经明确授权不得转售。